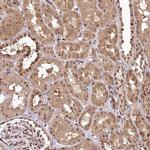
PYROXD1 Antibody in Immunohistochemistry (IHC)

Search
Invitrogen
PYROXD1 Polyclonal Antibody
{{$productOrderCtrl.translations['antibody.pdp.commerceCard.promotion.promotions']}}
{{$productOrderCtrl.translations['antibody.pdp.commerceCard.promotion.viewpromo']}}
{{$productOrderCtrl.translations['antibody.pdp.commerceCard.promotion.promocode']}}: {{promo.promoCode}} {{promo.promoTitle}} {{promo.promoDescription}}. {{$productOrderCtrl.translations['antibody.pdp.commerceCard.promotion.learnmore']}}

Please note: We are reviewing Western blot images included in the antibody testing data in our catalog, including those provided by third parties. Unless expressly labeled or annotated as “raw-unedited”, Western blot images included in the antibody testing data in our catalog may have been edited, optimized or otherwise adjusted for presentation.
产品信息
PA5-58341
种属反应
宿主/亚型
分类
类型
抗原
偶联物
形式
浓度
规格
纯化类型
保存液
内含物
保存条件
运输条件
RRID
产品详细信息
Immunogen sequence: MCEVKKIYLQ DEFRILKKKS FTFPRDHKSV TADTEMWPVY VELTNEKIYG CDFIVSATGV TPNVEPFLHG NSFDLGEDGG LKVDDHMHTS LPDIYAAG
Highest antigen sequence identity to the following orthologs: Mouse - 80%, Rat - 81%.
靶标信息
The PYROXD1 gene encodes the protein pyridine nucleotide-disulphide oxidoreductase domain 1, which has a significant role in mitochondrial function and cellular redox homeostasis. This gene is involved in maintaining the balance of oxidative stress within cells and is crucial for the redox regulation of cellular components, impacting processes like energy metabolism and apoptosis. Mutations in PYROXD1 have been associated with early-onset myopathy, indicating its importance in muscle development and maintenance. The protein encoded by PYROXD1 is part of the oxidoreductase enzyme family that facilitates electron transfer, contributing to cellular defense against oxidative damage. Recent studies have linked PYROXD1 to various neuromuscular disorders, where disruptions in its function affect muscle fiber alignment and force production. Understanding its role in redox biology is crucial for developing therapeutic strategies to combat muscle pathologies and redox-related diseases.
仅用于科研。不用于诊断过程。未经明确授权不得转售。
篇参考文献 (0)
生物信息学
蛋白别名: FLJ22028; Pyridine nucleotide-disulfide oxidoreductase domain-containing protein 1; tRNA ligase complex-associated NAD(P)H dehydrogenase PYROXD1
基因别名: PYROXD1
Entrez Gene ID: (Human) 79912




